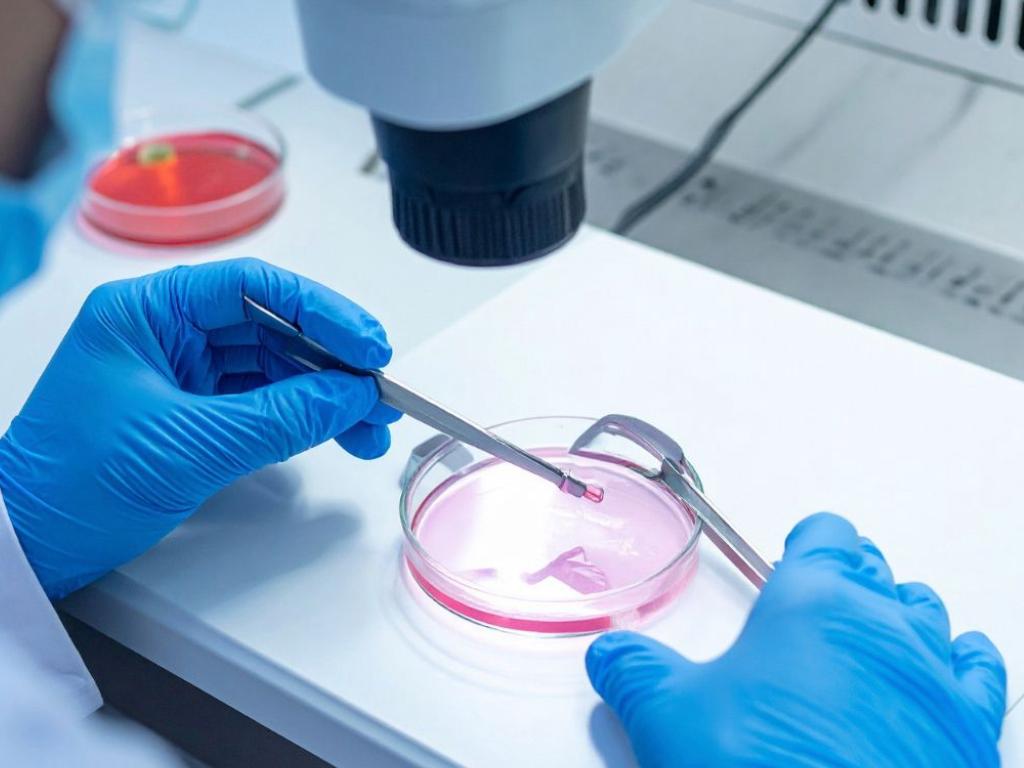

Khám phá
- Du lịch & Chất lượng sống
- Chọn theo Gu
- Chủ đề yêu thích
- Loại hình du lịch
- Tour Hop on Hop off
- Tour trong ngày
- Tour ghép hàng ngày
- Tour Học đường & kỹ năng
- Du lịch Y Tế
- Tour Free & Easy
- Tour gia đình
- Tour văn hóa & lịch sử
- Tour mạo hiểm
- Tour dã ngoại
- Tour chơi Golf
- Tour nghỉ dưỡng biển
- Tour du thuyền
- Du lịch kết nối thương mại & trải nghiệm sản xuất
- Tour Lễ - Tết
- Du lịch thân thiện & bền vững
- Trợ lý du lịch
- Cộng đồng & Hội viên
Quay lại
Du lịch & Chất lượng sống
Quay lại
Chọn theo Gu
Chọn theo Gu
Chủ đề yêu thích
Chủ đề yêu thích
Chọn theo Gu
Loại hình du lịch
Loại hình du lịch
Hồ sơ